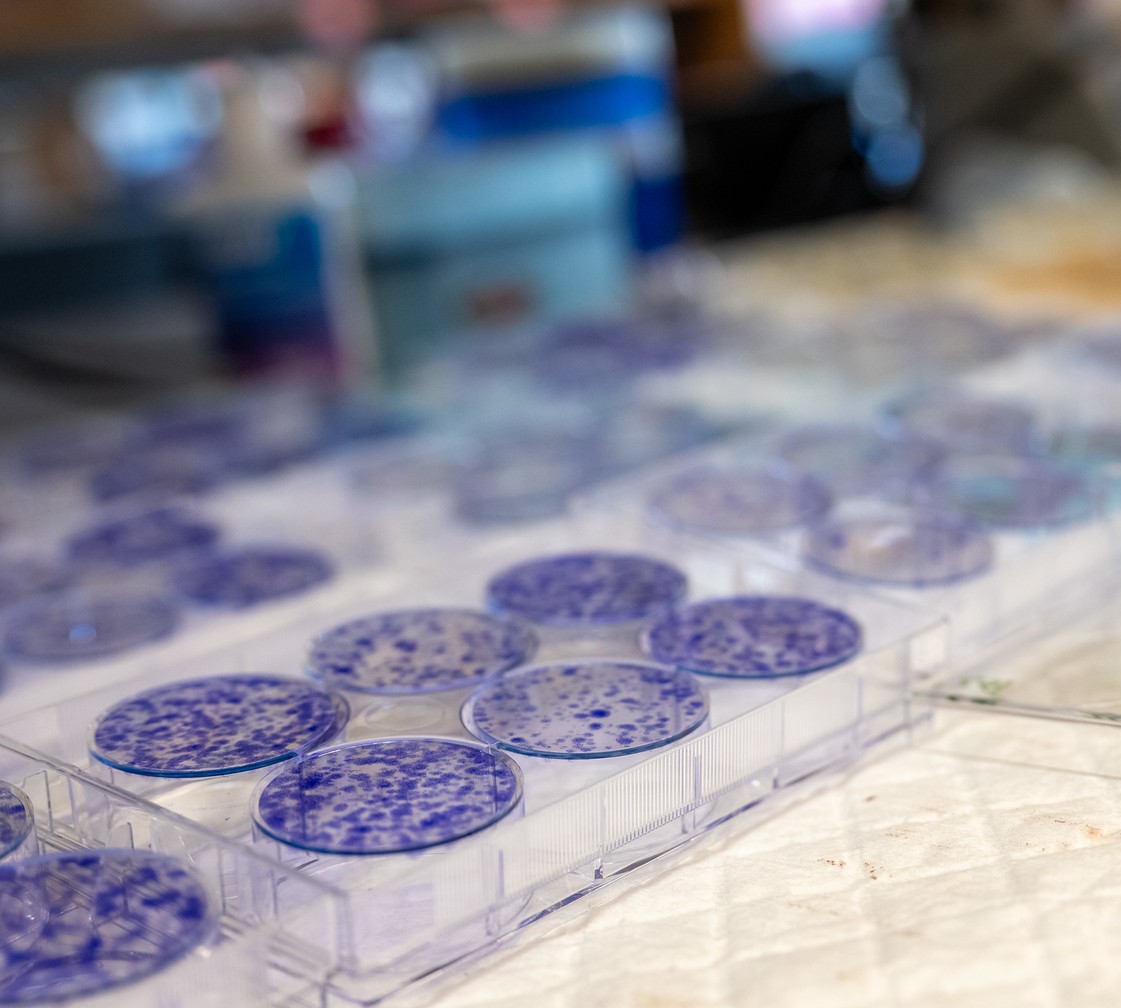
cancer-lab

The Region’s Only Cellular Therapy Program
Wilmot is home to the region’s only Cellular Therapy Program. This program builds on Wilmot’s expertise in Blood and Marrow Transplantation to provide a special kind of cancer treatment called CAR T-cell therapy.
Wilmot is home to the region’s only Cellular Therapy Program. This program builds on Wilmot’s expertise in Blood and Marrow Transplantation to provide a special kind of cancer treatment called CAR T-cell therapy.
What is CAR T-cell Therapy?
CAR T-cell therapy stands for Chimeric Antigen Receptor therapy. It is a type of treatment that uses immune cells — instead of blood-forming stem cells —to improve the body’s ability to fight cancer.
How does CAR T-cell Therapy work?
In CAR T-cell therapy, your immune system cells, called T-cells, are collected and changed in the laboratory so that they will attack cancer cells.
First, the T cells are taken from your blood through apheresis, a process that involves removing whole blood and then separating it into various components. The T cells are then sent to a laboratory and the remainder of your blood is returned to your body.
In the laboratory, a special gene is added to the T cells that enables them to recognize and attack cancer cells. These modified immune cells — now called CAR T cells — are grown in large numbers in the laboratory and are then infused back into your bloodstream.
After the infusion, our team monitors you closely for side effects and will make sure your condition is stable before you are discharged from the hospital and local area.
Who is Eligible for CAR T-cell Therapy?
CAR T-cell therapy is a new type of cancer treatment that is not for everyone. It is only approved to treat two groups of people with certain types of cancer:
- Children and adults with precursor B-cell acute lymphoblastic leukemia (ALL) that hasn't gotten better with treatment or that’s come back after treatment.
- Adults with aggressive large B-cell lymphoma or mantle cell lymphoma that hasn't gotten better with treatment or that’s come back after treatment.